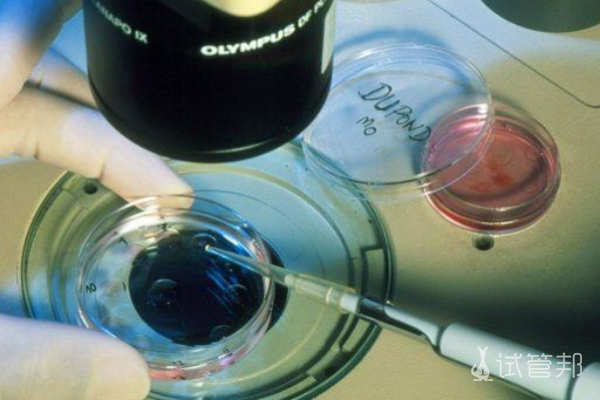
1e711b7d0e25aeb433846321f2ff093e.png 中国做试管婴儿成功率有47.24%吗

中国做试管可以选性别吗,做试管婴儿成功率有47.24%吗
近年来,随着科技的不断进步,试管婴儿技术在中国逐渐成为解决不孕不育问题的主要手段之一。随之而来的问题是,中国是否允许通过试管婴儿技术选择胚胎的性别?而试管婴儿的成功率是否真的高达47.24%?本文将深入探讨这些问题,剖析试管婴儿技术在中国的现状与发展趋势。

做试管全部流程需要几个月
试管婴儿通常是指体外受精-胚胎移植这一辅助生殖技术。一般而言,完成整个体外受精-胚胎移植的流程通常需要3个月到6个月的时间。
体外受精-胚胎移植是一项辅助生殖技术,其主要过程包括卵子和精子的提取,然后在体外完成受精,培养成胚胎后再植入子宫腔内,是一种帮助不孕不育患者实现妊娠的方法。手术步骤主要包括取卵、体外受精、胚胎移植等环节。若女性身体状况良好且卵巢功能正常,可能在2个月内完成整个生育周期;然而,對於身體素質較差或存在內分泌紊亂的女性來說,可能需要更长时间来完成整个过程。因此,确切的时间仍需根据个体情况来判断。
做试管可以选择孩子性别吗
在中国,试管婴儿的性别选择除非存在医学指征,如性染色体遗传疾病等,否则是被明确禁止的,违反了法律和国家政策。因此,在进行试管婴儿时,除非有必要,是不被允许主观选择胚胎的性别的。对于一些伴性遗传病,如血友病、蚕豆病等,可以通过试管婴儿技术进行遗传学诊断,在胚胎植入前筛查没有致病基因的胚胎,从而预防婴儿患上遗传病的可能性。
做试管成功率是多少
试管婴儿的成功率因个体身体状况而异:
1、成功率可能高达60%~70%:对于由于单一因素,如输卵管问题引起的不孕情况,身体状况较佳的个体可能享有较高的成功率。
2、成功率可能降至20%~40%:对于夫妻双方身体状况影响引起的不孕,成功率可能较为有限。
试管婴儿技术在中国取得了显著的发展,为许多不孕不育夫妇带来了希望。而在追求试管婴儿成功率的过程中,夫妇需充分了解自身情况,选择合适的医生和生育技术,以提高成功的可能性。在未来,随着科技的不断进步和法规的不断完善,相信試管嬰兒技術將為更多夫婦實現生育夢想提供更多可能。
-
试管婴儿高成功率
点击查看
-
试管婴儿费用/流程
获取详情
-
第三代试管医院
汇总收藏
-
试管婴儿补贴
领取优惠